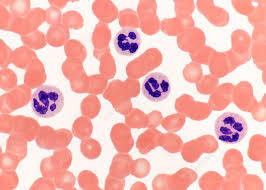

What is a light microscope?
Instrument that uses visible light and glass lenses to enable the user to see objects magnified
Image produced by light microscope
Blood smear
What is a compound light microscope?
Instrument that magnifies an object using two lenses.
-Eyepiece lens: closest to eye
-Objective lens: closest to specimen
Label a compound microscope?


What is a dry mount?
-Solid specimens
-Sectioned
-Specimen place on centre of slide
-Cover slip placed on top
What is a wet mount?
-Specimen suspended in liquid
-Cover slip placed on at angle
What is a squash slide?
-Wet mount prepared
-Lens tissue/ microscope slide used to press down cover slip
What is a smear slide?
-Edge of slide used to smear sample
-Creating thin, even coating
-Coverslip placed on top
How do you prepare a sample for staining?
-Placed on slide
-Allow to air dry
-Heat-fixed by passing through flame
-Specimen adheres to microscope and takes up stain
Rules for biological drawings
-Include a title
-State magnification
-Sharp pencil line
-White, unlined paper
-Use majority of space
-Smooth, continuous line
-No shading
-Draw clearly defined structures
-Label lines should not cross or have arrowheads
-Label lines should be drawn with a ruler, parallel to the top of the page

What is differential staining?
Using specific stains to distinguish between different types of cells/cellular components
What is fixing?
Chemicals used to preserve specimens
What is sectioning?
Specimens dehydrated with alcohols
Placed in mould with wax/resin to form hard block
Can be thinly sliced with knife
What is mounting?
Specimens secured to microscope slide and cover slip placed on top
What is magnification?
To produce an image of an object at a scale larger than its actual size.
Formula for magnification
Magnification = size of image / actual size of object
M = I / A
What is resolution?
Shortest distance between two objects that are still seen as separate objects
Ability to distinguish between two points as separate
1 micrometre in nanometres
1000nm
1 millimetre in micrometres
1000
What is an electron microscopy?
Microscopy using a microscope that employs a beam of electrons to illuminate the specimen
(higher resolution due to smaller wave length)
What is the measurement of each division on a micrometer slide?
100 divisions = 1mm
1 division = 0.01mm = 10 micrometers
What is a stage micrometer?
Microscope slide marked with an accurate scale in micrometers
What is an eyepiece graticule?
Glass disc marked with a fine scale from 1-100
Has no units
How do you use an eyepiece graticule to calibrate a light microscope?
1) Put stage micrometer in place and eyepiece graticule in eyepiece
2) Get the scale on the micrometer slide in focus
3) Align the micrometer scale with the scale in eyepiece
4) Take readings from the two scales
5) Calibrate the micrometer











